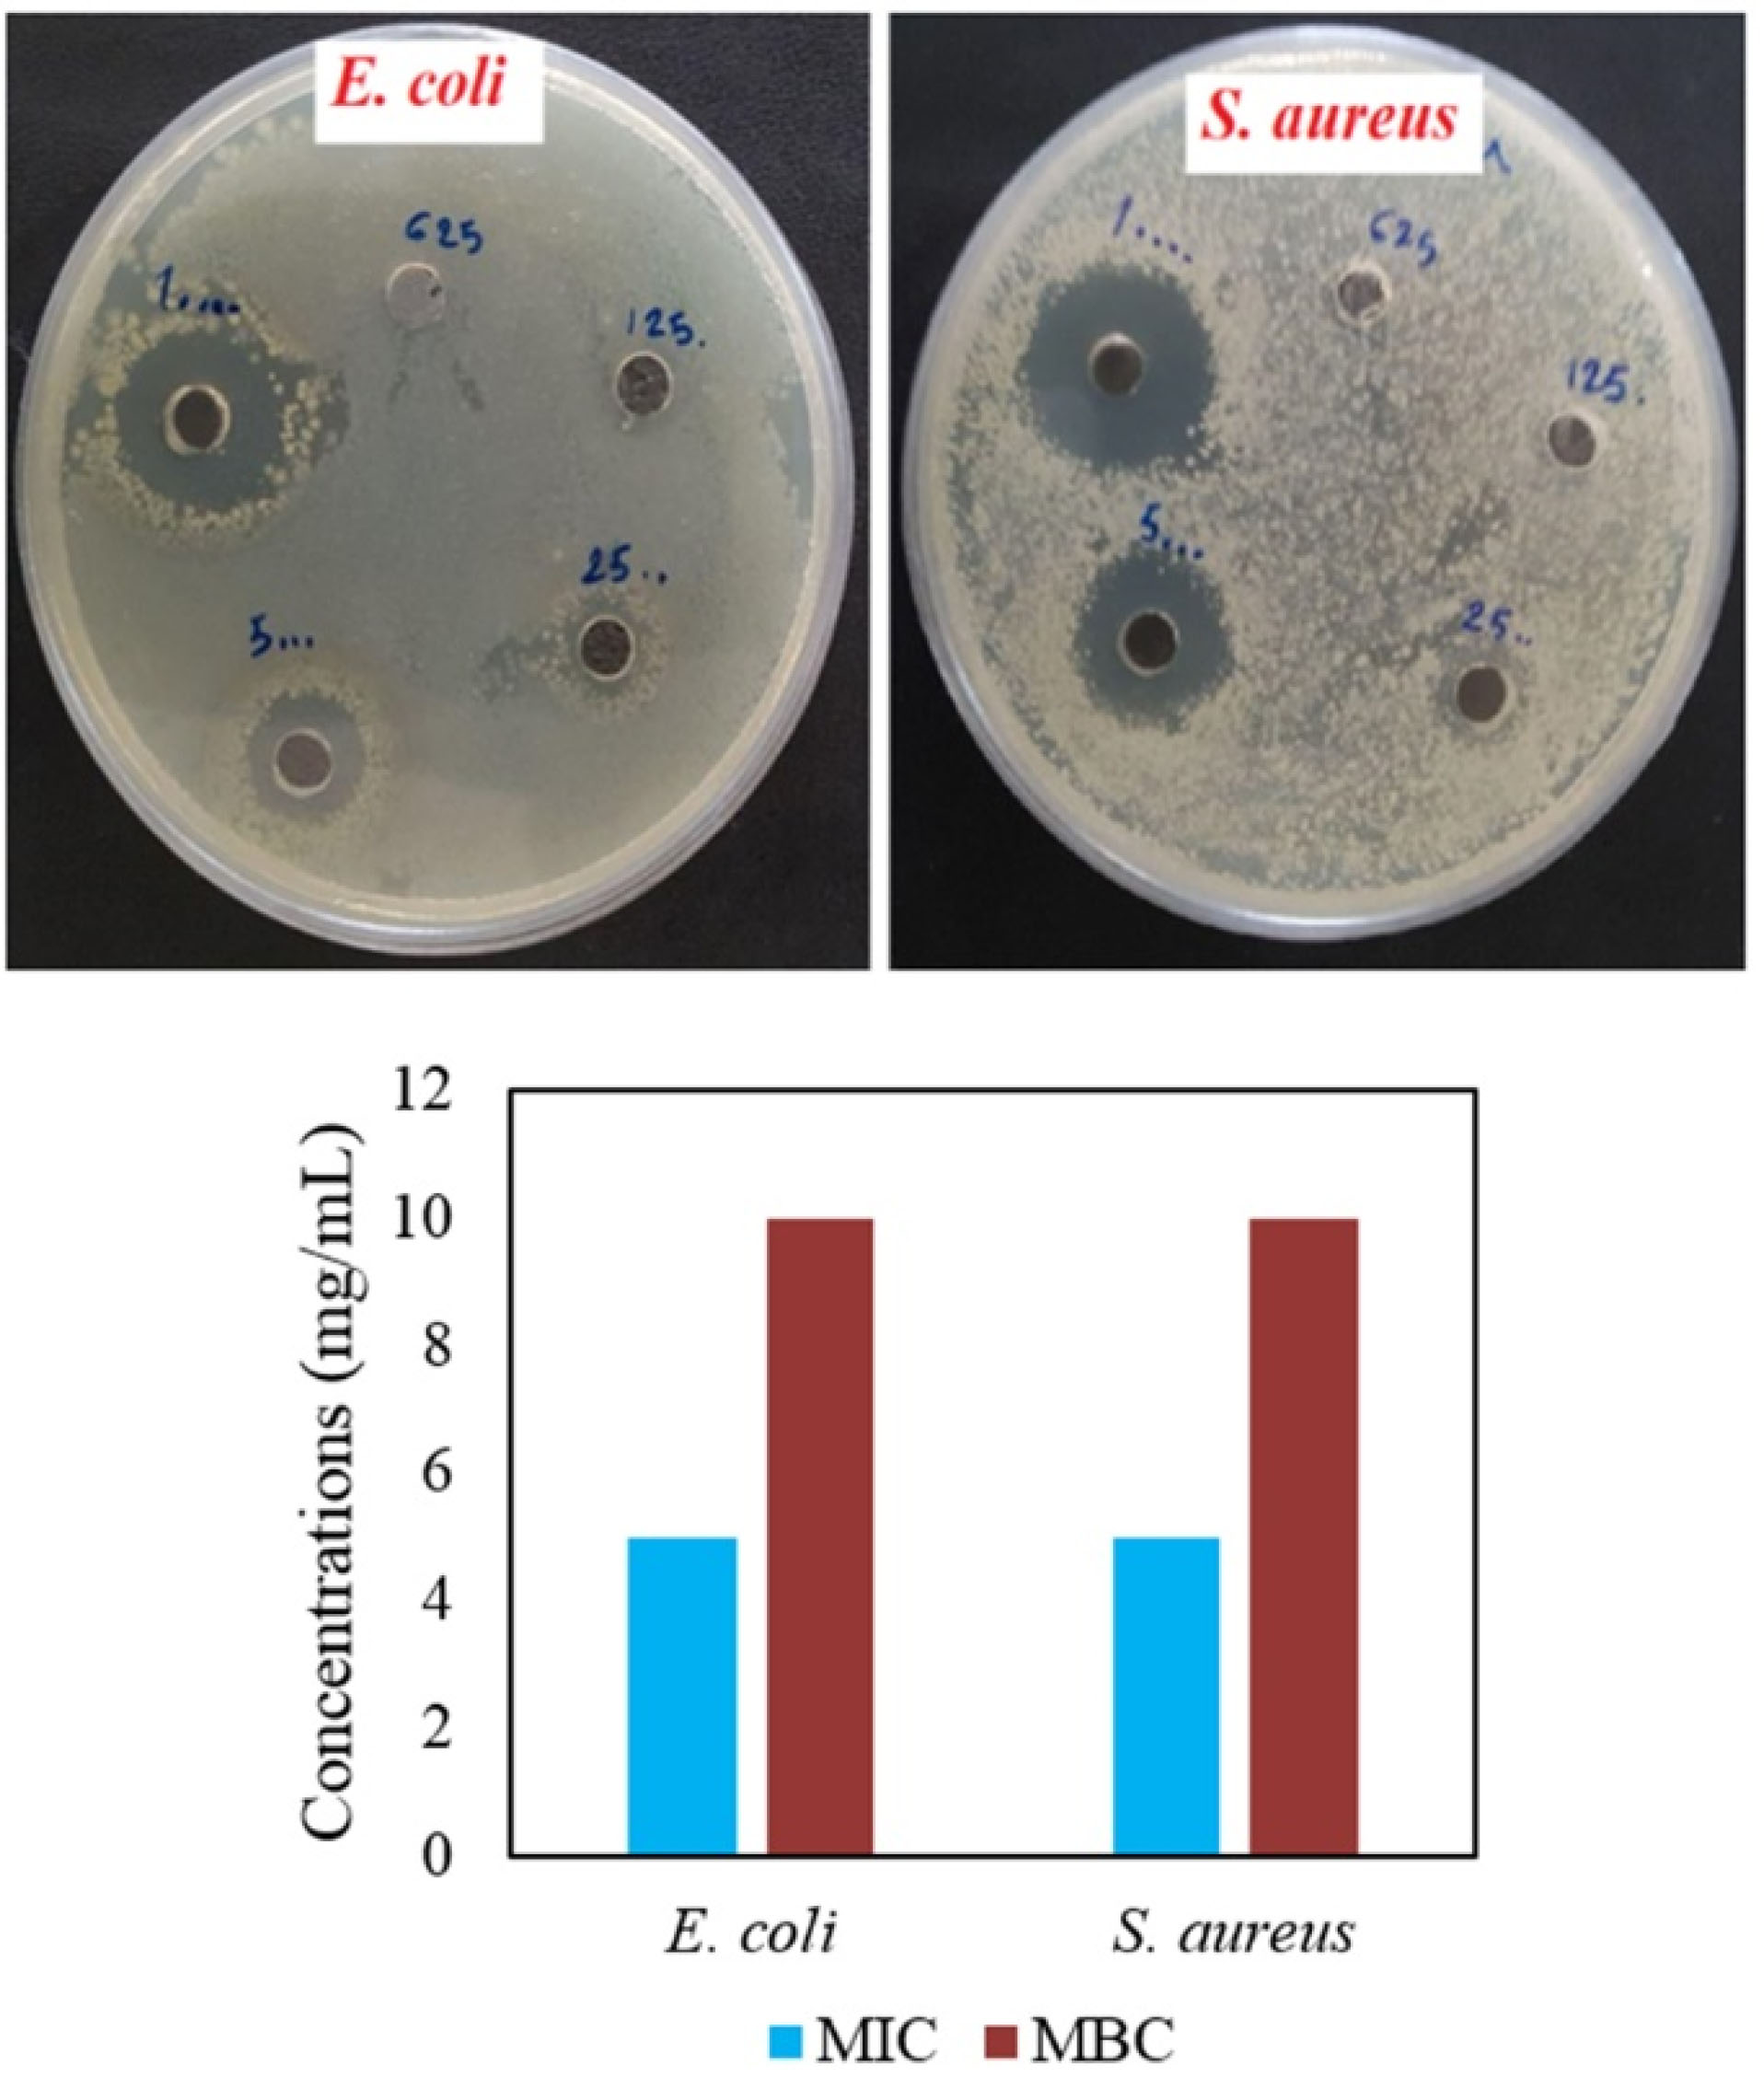
apb-11-497-g006

Advanced pharmaceutical bulletin. 11(3):497-504.
doi: 10.34172/apb.2021.057
Research Article
Antibacterial Activities of Phytofabricated ZnO and CuO NPs by Mentha pulegium Leaf/Flower Mixture Extract against Antibiotic Resistant Bacteria
Mehran Alavi 1, 2, *  , Saeed Dehestaniathar 1, *
, Saeed Dehestaniathar 1, *  , Shadieh Mohammadi 1, Afshin Maleki 1, Naser Karimi 2
, Shadieh Mohammadi 1, Afshin Maleki 1, Naser Karimi 2
Author information:
1Environmental Health Research Center, Research Institute for Health Development, Kurdistan University of Medical Sciences, Sanandaj, Iran.
2Nanobiotechnology Laboratory, Biology Department, Faculty of Science, Razi University, Kermanshah, Iran.
Abstract
Purpose:
In this study, leaf/flower aqueous extract of medicinal plant species Mentha pulegium was used to synthesize ZnO and CuO nanoparticles (NPs) as a cost-effective, one-step, and eco-friendly method.
Methods:
Physicochemical properties of both metal oxide NPs (MONPs) were determined by UV-Vis spectroscopy, X-ray diffraction (XRD), Fourier-transform infrared (FTIR) spectroscopy, scanning electron microscope (SEM) and energy dispersive X-ray (EDX) techniques.
Results:
Phytofabricated ZnONPs and CuNPs illustrated 65.02±7.55 and 26.92±4.7 nm with antibacterial activities against antibiotic-resistant Escherichia coli and Staphylococcus aureus. Higher antibacterial activities were observed for CuONPs compared with ZnONPs.
Conclusion:
Large surface area and more reactivity resulted from smaller size as well as higher production of reactive oxygen species (ROS) were considered to antibacterial efficiency of CuONPs against antibiotic-resistant E. coli and S. aureus.
Keywords: Phytosynthesis, Metal oxide NPs, Mentha pulegium, Antibiotic resistance, Antibacterial activities
Copyright and License Information
©2021 The Authors.
This is an Open Access article distributed under the terms of the Creative Commons Attribution (CC BY), which permits unrestricted use, distribution, and reproduction in any medium, as long as the original authors and source are cited. No permission is required from the authors or the publishers.
Introduction
Infectious diseases resulted from antibiotic-resistant microorganisms specifically multidrug-resistant (MDR) bacteria are increasing owing to the inefficiency of conventional antibiotics.
1
Several mechanisms including higher expression of efflux pump and antibiotic degradable enzymes are recognized for this ability in bacteria.
2
In recent years, nanotechnology has illustrated the appropriate antibacterial capacities of metal nanoparticles (MNPs)/metal oxide NPs (MONPs) compared to their bulk materials and common antibiotics.
3
These abilities can be resulted from unique properties such as higher aspect ratio and surface area to volume ratio of these nanomaterials (NMs) compared with bulk materials. In this case, antibacterial activities of MNPs/MOPNs against MDR bacteria have been reported by various investigations.
4
ZnO and CuO NPs with less cytotoxicity compared to other MNPs/MONPs such as Ag NPs may be a suitable option to obtain efficient antibacterial formulation.
5,6
Ions released by these MONPs are defined as a major antibacterial mechanism which can disrupt the integrity of cell envelope of bacteria.
7
In addition, the antibacterial and biocompatibility of these NPs can be modified by several approaches. For instance, green synthesis of ZnO and CuO NPs by medicinal plant extracts can decrease cytotoxicity and increase therapeutic applications of these MONPs.
8,9
For this purpose, there are many studies related to phytosynthesis of Ag, Cu, CuO, ZnO, and Fe3O4 NPs with antibacterial effects on sensitive and MDR bacteria.
3
In this regard, green synthesized TiO2, Fe3O4, ZnO, Cu, and Ag NPs by Artemisia haussknechtii plant species demonstrated average diameter size of 92.58, 83.4, 60, 35.36 and 10.69 nm with antibacterial activities against Gram-positive and Gram-negative bacteria.
10-12
In this study, we used Mentha pulegium plant species to synthesize ZnO and CuO NPs. M. pulegium is flowering plant in Mentha genus of Lamiaceae family which can be found widely in Middle East, North Africa and Europe regions as native species. Stems, leaves and flowers of this plant species have antiseptic activities against wide range of microorganisms.
13,14
Result of disc diffusion assay for essential oils of M. pulegiumagainst E. coli and S. aureus showed inhibition zone diameters (IZDs) by 12.6±0.5 and 21.4±0.8 mm respectively.
15
In previous study, leaves extracts of M. pulegiumwere used to prepare AgNPs with size distribution in the range 5-50 nm. These MNPs demonstrated antibacterial effects on E. coli, S. aureus and Streptococcus pyogenes bacteria.
16
In fact, both flower and leaf extracts of M. pulegiumhave shownantimicrobial properties.
17,18
These abilities can be resulted from various oxygenated monoterpenes in secondary metabolites of this plant species.
15
According to above argument, we used leaf/flower aqueous extract to fabricate ZnO and CuO NPs. After characterization of physicochemical properties of these MONPs by standard techniques, antibacterial activities of each MONP against antibiotic-resistant E. coli and S. aureus were determined by disc diffusion, agar well diffusion, minimum inhibition and bactericidal concentrations (MIC/MBC) assays. In the case of the bacterial loading on the glass surface, ATP-bioluminometer instrument was applied to measure cell number upon MONPs stress.
Materials and Methods
Materials
All materials obtained from commercial sources were utilized without further purification. Zinc nitrate [Zn(NO₃)₂ •6H2O], copper(II) sulfate (CuSO4), nutrient agar (NA), Mueller-Hinton agar (MHA), Mueller-Hinton broth (MHB) and peptone water (PW) are purchased from Sigma-Aldrich chemicals company (St. Louis, MO). Antibiotic discs were purchased from PADTAN TEB Company, Tehran, Iran.
Preparation of Leaf/flower extract
Healthy leaves of M. pulegium were sampled from the Amrooleh mountainous region, in the Kermanshah province, west of Iran during July 2019 followed by identification and authentication by an expert of Kurdistan agriculture and resource research center (Sanandaj, Kurdistan). Aqueous leaf/flower extract of M. pulegium was obtained by freshly amassed leaf/flower (10 g). The leaves and flower surface were cleaned with running tap water, followed using distilled water, and air dried on a paper towel for 2 weeks. Dry leaves and flowers were grounded in a tissue grinder to get fine powder, and boiled with 150 mL of double distilled water at 60°C for 1 hour. The filtered suspension was collected and stored at 4°C till further use.
Phytosynthesis of CuO and ZnO NPs
In order to phytosynthesize CuO and ZnO NPs, the Erlenmeyer flask with 100 mL volume of CuSO4 and [Zn(NO₃)₂ •6H2O] salts by 0.1M concentrations were stirred for 3 hours at 25○C. The aqueous leaf/flower extract of M. pulegiumwas filtered via Whatman No. 1 filter paper followed by centrifugation at 5000 rpm for 1h. Twenty mL of resulted leaf/flower aqueous extract samples were separately added to 80 mL of CuSO4 and [Zn(NO₃)₂ •6H2O] at room temperatures under stirred condition for 24 hours. In order to purify NPs, mixture solutions were centrifuged at 4000 rpm for 30 minutes. After drying the colloidal solution, the resulting powder was crushed and subsequently the obtained sediment was washed repeatedly with absolute ethanol and deionized water. In the case of ZnO NPs synthesis, the samples were calcined at 400°C to obtain the powder for subsequent analyses.
19
Physicochemical characterization
UV-Vis spectroscopy (Tomas, UV 331), X-ray diffraction (XRD) analysis (model PW1730, PHILIPS, Netherlands), Fourier-transform infrared (FTIR) spectroscopy (AVATAR, Thermo, United States), and FE-SEM (MIRA III, TESCAN, Czechia) technique were applied to determine physicochemical properties of ZnO and CuONPs. Zeta potentials of each NP were indicated by DLS (model ZEN3600, MALVERN, United Kingdom). The intensities related to absorption peaks of ZnO and CuONPs were examined by UV-Vis spectroscopy in the wavelength range of 200 to 600 nm. XRD was applied in the scanning range of 10°-80°(2θ) using Cu Ka radiations of wavelength 1.5406 Å for identification of the crystal phases and determination of the average crystal size of NPs.
Antibacterial activities
Bacteria species
Escherichia coli and S. aureus, as respectively gram-negative and gram-positive bacteria species were obtained from Kowsar hospital, Kurdistan University of Medical Sciences, Sanandaj, Iran. In order to determine the sensitivity of these species, after culturing of bacteria on NA medium and incubation for 24 hours at 37○C, antibiotics including amoxicillin, azithromycin, ciprofloxacin, cefixime, doxycycline, gentamycin, and sulfamethoxazole as the amount of 10 µg/disc were tested on these bacteria (Table 1).
Table 1.
Disc diffusion (IZD (mm) ± SD) results for antibiotics sensitivity of E. coli and S. aureus (R=resistance). Values are averages of three independent analyses plus SD (n = 3)
|
Antibiotic type
|
E. coli
|
S. aureus
|
| Amoxicillin |
R |
46.13 ± 1.02 |
| Azithromycin |
R |
21.46 ± 0.5 |
| Cefixime |
R |
19.9 ± 0.17 |
| Ciprofloxacin |
R |
R |
| Doxycycline |
R |
R |
| Gentamycin |
21.8 ± 0.72 |
40.33 ± 0.57 |
| Sulfamethoxazole |
R |
R |
Agar well diffusion and MIC/MBC assays
Broth cultures of S. aureus and E. coli as cell density ≈ 1.5 × 108 CFU/mL (standardized by 0.5 McFarland standard) were prepared in the PW medium with the concentration of 0.1%. The bacteria species were swabbed on the MHA plate. Wells (6 mm) were made with a sterile metal punch on the surface of the agar plates. Wells were filled by 50 µL of ZnO and CuONPs with serial concentrations of 0.625, 1.25, 2.5, 5, and 10 mg/mL followed by incubation at 37○C for 24 hours. IZDs were measured by calipers as averages of three independent analyses plus standard deviation.
20
Minimum bacteriostatic and bactericidal concentrations of both NPs were indicated by MIC and MBC respectively. Firstly, the standard cell density of bacteria (0.5 McFarland) was cultured in 96-well microplate. Concentrations of NPs were varied via two-fold serial dilution (0.625, 1.25, 2.5, 5, and 10 mg/mL). The wells were monitored for turbidity as growth and non-turbidity as no growth following incubation of medium for period of 1 day at 37°C. 10 μL of the samples of each tube with no growth of bacteria were sub cultured onto the agar. The MIC results were indicated as the lowest concentration of the sample, which demonstrated clear fluid with no development of turbidity. Moreover, the MBC was determined as the highest dilution of each NP that did not generate a single bacterial colony on MHA after 1 day incubation period.
12
Statistical analysis
Statistical evaluating of results were performed by SPSS version16 software (SPSS Inc., Chicago, IL) and one way ANOVA (Tukey’s test) respectively. Results were presented in triplicates and averages plus standard errors were assessed as P≤0.05 of significant value.
ATP-bioluminometer
ATP-bioluminometer (UltraSnapTM-Surface ATP) is used to determine bacterial loading on the environmental surfaces and medical equipment.
21,22
For this purpose, NP with higher antibacterial activities was selected to measure bacterial removal ability from the infected surface. It should be considered that E. coli bacteria were more resistance to antibiotic compared to S. aureus. Four glass slides were sterilized in 150○C for 120 minutes followed by an addition of 100 µL of E. coli to each slide. The initial cell number of bacteria was measured as amount as 3673 by ATP-bioluminometer. Afterwards, volumes of 25, 50, and 100 µL of NPs with 5 mg/mL value were incubated on the surface of slides containing bacteria. One slide without NPs was considered as the control sample and cell number was obtained after 15 minutes.
Results and Discussion
UV-Vis spectroscopy and zeta potential
The formation of MONPs can be determined by their surface plasmon absorption band. UV-Vis spectra for ZnO and CuONPs showed peaks at 255 and 278 nm wavelengths respectively (Figure 1). In a similar study, there was a peak at 370 nm for green synthesized ZnO NPs by Artemisia haussknechtii, medicinal plant species.
19
The maximum absorbance for biosynthesized CuONPs via Malus domestica leaf extract was at 335 nm wavelength.
23
The absorption band at 366 nm was found for green prepared ZnONPs via Catharanthus roseus leaf extract.
24
Electrokinetic potentials of both NPs in colloidal dispersion were indicated by zeta potential results. ZnONP demonstrated -7.14 mV and 4.96 mS/cm for zeta potential and conductivity respectively. Also, the values of zeta potential and conductivity were respectively -3.45 mV and 3.43 mS/cm for CuONPs. In contrast, the positive charge of zeta potential as the amount of 2.61 mV was found for phytosynthesized ZnONPs using Solanum torvum leaf extract.
25
Similarly, there was a negative charge of zeta potential around -30 mV at pH≈7 for green synthesized CuONPs by leaf extract of Punica granatumplant species.
26

Figure 1.
UV-Vis spectra (a) and zeta potential graphs (b) of green synthesized ZnO and CuO NPs with related peaks.
.
UV-Vis spectra (a) and zeta potential graphs (b) of green synthesized ZnO and CuO NPs with related peaks.
XRD results
As shown in Figure 2a and 2b, XRD analysis illustrated crystalline structures and phases of ZnO and CuONPs. The sharp peaks at (100), (002), (101), (102), (110), (103) and (112) were corresponded to 2θ values of 32○, 34.69○, 36.49○, 47.79○, 56.78○, 63.09○ and 68.24○ respectively (Figure 2a). Similar diffraction lattice planes by the hexagonal wurtzite structure were observed at 31.46○, 34.29○, 36.33○, 47.51○, 56.50○, 62.84○ and 67.79○ for green synthesized ZnONPs via Laurus nobilis leaves aqueous extract.
27
As illustrated in Figure 2b, in the case of CuONPs, there was a crystallite structure of face-centered cubic structure (FCC) by the peaks at 35.20○, 38.66○, 47.50○ and 53.99○ for the planes of (002), (111), (-202) and (020) respectively.
28
These planes were indicated for prepared CuONPs by aqueous extract of oak fruit hull.
29
The obtained crystal size of ZnONPs and CuONPs were respectively 18.09 and 18 nm. Hexagonal morphology of ZnO NPs with 36.83 nm grain size was observed in the case of phytofabricated ZnONPs via C. roseus plant leaf extract.
24
Phytosynthesized ZnONPs by A. haussknechtii leaf aqueous extract showed an average crystal size of 53 nm.
19
In addition, CuONPs biosynthesized by Halomonaselongata IBRC-M 10214 demonstrated grain size in the range of 57-79 nm.
30
According to the present results, grain sizes of our NPs were smaller compared to similar previous investigations.

Figure 2.
XRD patterns of green synthesized ZnO NPs (a) and CuO NPs (b).
.
XRD patterns of green synthesized ZnO NPs (a) and CuO NPs (b).
FTIR spectra
FTIR spectra of ZnO and CuONPs are presented in Figure 3a and 2b. Prominent peaks at 3435.74 and 3423.06 cm-1 were related to -OH stretching vibration, which can be associated to water adsorption on NPs surface. In the case of ZnONPs, peaks at 1382.34, 1116.70 and 519.94 cm-1 wavenumber were corresponded to C-H bending (aldehyde and alkane), C-O stretching (tertiary alcohol and aliphatic ether) and C-I stretching (halo compound) respectively (Figure 3a). For CuONPs, sharp and intense peaks were at 1627.64, 1101.71 and 600.41 cm-1 respectively related to C=C stretching (alkene), C-O stretching (secondary alcohol and aliphatic ether) and C-Br stretching (halo compound) (Figure 3b). Similar peaks also were indicated to green synthesized ZnO and CuONPs by Abelmoschus esculentus mucilage and algal extract respectively.
31,32
These functional groups may be resulted from the interaction of MONPs with primary and secondary metabolites of leaf extract.
33
C-O stretching (secondary alcohol and aliphatic ether) and C-O stretching (tertiary alcohol and aliphatic ether) were a common functional group for both CuO and ZnONPs. This functional group can be resulted from the presence of secondary metabolites containing alcohol and aliphatic ether in leaf/flower extract.
34
In addition, these peaks may be responsible for the stabilization of ZnO and CuONPs.
35

Figure 3.
FTIR spectra related to phytosynthesized ZnONPs (a) and CuONPs (b).
.
FTIR spectra related to phytosynthesized ZnONPs (a) and CuONPs (b).
SEM and EDX analyses
According to the results of SEM images, spherical shape was a common shape of ZnO and CuO NPs (Figure 4a and 4b). Average diameter sizes for ZnO and CuO NPs were respectively 65.02±7.55 and 26.92±4.7 nm (Figure 4c). As shown in Figure 5, EDX analysis of ZnONPs showed respectively 77.98%, 12.25%, 4.85%, and 3.05% for Zn, O, C and K elements (Figure 5a). As illustrated in Figure 5b, elemental weights of CuONPs were 51.39%, 21.49%, 13.91%, 9.91% and 3.31% for O, C, Cu, S and K respectively. Oxygen, carbon and potassium elements were common in green synthesis of these MONPs by M. pulegium. Contribution of carbon, phosphor and sulfur indicated for green synthesized CuONPs using Malus domestica leaf extract.
23
In addition to zinc and oxygen, lichen synthesized ZnONPs by P. muralis showed sulfur and chlorine elements in the EDX spectrum.
36

Figure 4.
SEM images of ZnO NPs (a) and CuO NPs (b). Average diameter sizes of each NP (c)
.
SEM images of ZnO NPs (a) and CuO NPs (b). Average diameter sizes of each NP (c)

Figure 5.
EDX spectra of green synthesized ZnO NPs (a) and CuO NPs (b) with related elemental maps.
.
EDX spectra of green synthesized ZnO NPs (a) and CuO NPs (b) with related elemental maps.
Agar well diffusion and MIC/MBC assays
Agar well diffusion showed antibacterial activities of CuONPs contrast to ZnONPs with any antibacterial effects in all concentrations (Table 2 and Figure 6). At lower amounts of CuONPs (0.625 and 1.25 mg/mL), both bacteria showed resistance. In a comparative way, S. aureus demonstrated higher sensitivity than E. coli. At a higher concentration (10 mg/mL), IZD values of 17.56±0.4 and 20.96±0.45 mm were observed for E. coli and S. aureus respectively (Table 2). In the previous study, streptomycin antibiotic and phytosynthesized Cu/Cu2O NPs via Stachys lavandulifolia flowers aqueous extract showed 14 and 12 mm IZDs in the case of Pseudomonas aeruginosa bacteria.
37
Green synthesized CuONPs with 22-25 nm crystallite size via mint leaf extract showed 38 and 35 mm IZDs for Bacillus subtilis and E. coli bacteria respectively.
38
Biosynthesized CuONPs by Bacillus sp. FU4 demonstrated IZD of 33±0.57 mm toward E. coli ATCC 25922.
39
There were IZD values by 10 and 11 mm for respectively E. coli and S. aureus bacteria upon biosynthesized CuONPs via Halomonaselongata IBRC-M 10214.
30
Prepared CuONPs by different methods involving chemical precipitation, microwave irradiation, and hydrothermal methods showed respectively 27 mm, 25 mm, and 22 mm IZDs against S. aureus.
40
For both bacteria, MIC and MBC assays illustrated respectively 5 and 10 mg/mL concentrations. MIC and MBC amount for synthetic CuONPs (with a diameter of 48 ± 7 nm) was >100 µg/mL toward Salmonella Typhimuriumbacteria.
41
Table 2.
Results of agar well diffusion (IZD (mm) ± SD) for CuONPs against E.coli and S. aureus bacteria
|
Concentration (mg/mL)
|
E. coli
|
S. aureus
|
| 0.625 |
- |
- |
| 1.25 |
- |
- |
| 2.5 |
6.46 ± 0.152 |
7.66 ± 0.57 |
| 5 |
14 ± 0.5 |
16.5 ± 0.5 |
| 10 |
17.56 ± 0.4 |
20.96 ± 0.45 |
Figure 6.
Images showing IZDs for E. coli and S. aureus bacteria at serial two-fold dilution (625, 1250, 2500, 5000, and 10000 µg/mL) as well as MIC and MBC results.
.
Images showing IZDs for E. coli and S. aureus bacteria at serial two-fold dilution (625, 1250, 2500, 5000, and 10000 µg/mL) as well as MIC and MBC results.
ATP-bioluminometer
Growth of pathogenic microorganism particularly MDR bacteria on the hospital surfaces is a complicated issue, which should be removed to obtain a sterilized environment. Results of ATP-bioluminometer test illustrated the bactericidal activity of CuONPs at 50 and 100 µL compared to control and 25 µL of NPs (Table 3). The present study showed prominent antibacterial activities of phytosynthesized CuONPs by leaf/flower aqueous extract of M. pulegium medicinal plant. These findings can be resulted from antibacterial capacities related to plant metabolites as reducer/stabilizer agents and the ability of CuONPs to produce reactive oxygen species (ROS) in bacterial medium. In contrast to ZnONPs, the interaction of CuONPs with metabolites of M. pulegium led to synergism antibacterial activities. As illustrated in previous reports, hydrogen peroxide (H2O2), hydroxyl (*OH), superoxide (*O2-) and peroxide (*O2-2) are common ROS, which may be resulted in damage of bacterial envelope and biological macromolecules.
28,42,43
Table 3.
Antibacterial results of CuONPs on the glass slide after 15 minutes incubation
|
CuONPs volume (µL)
|
25 |
50 |
100 |
Control |
|
Bacteria number
|
368 |
0 |
0 |
2218 |
Conclusion
This study reported a one-pot, cost-effective, and eco-friendly method to synthesize ZnONPs and CuONPs by leaf/flower extract of M. pulegiummedicinal plant. The contribution of various metabolites in the stabilizing of MONPs was confirmed by FTIR spectra. C-O stretching (tertiary alcohol and aliphatic ether) and C-O stretching (secondary alcohol and aliphatic ether) were a common functional group for both ZnO and CuONPs. This functional group can be related to secondary metabolites containing alcohol and aliphatic ether with MONPs stabilization property. Based on the results of XRD spectra, the hexagonal wurtzite and FCC crystallite structures were determined for ZnO and CuO NPs respectively. Despite the similar shape (spherical) for both MONPs, there was a smaller size of CuONPs compared to ZnONPs. Antibacterial effects on antibiotic-resistant E. coli and S. aureus were higher for CuONPs in the face of ZnONPs. A large surface area as well as more reactivity of CuONPs rather than ZnONPs may be resulted in more ROS formation in the bacterial medium. The structural difference in the cell envelope of Gram-positive (cell wall and cell membrane) and Gram-negative (outer cell membrane, cell wall, and inner cell membrane) bacteria can impact on antibacterial capacities of MONPs. In the nutshell, M. pulegium medicinal plant can be a considerable option to ecofriendly phytosynthesize CuONPs with significant antibacterial activities toward pathogenic bacteria with antibiotic resistance property.
Ethical Issues
Not applicable.
Conflict of Interest
The authors declared no conflict of interest.
Acknowledgments
This article was extracted from a project supported by Kurdistan University of Medical Sciences (IR.MUK.REC. 1397/338). Hereby, we would like to express our gratitude to the sponsors of this study.
References
- Shin J, Prabhakaran VS, Kim KS. The multi-faceted potential of plant-derived metabolites as antimicrobial agents against multidrug-resistant pathogens. Microb Pathog 2018; 116:209-14. doi: 10.1016/j.micpath.2018.01.043 [Crossref] [ Google Scholar]
- Pang Z, Raudonis R, Glick BR, Lin TJ, Cheng Z. Antibiotic resistance in Pseudomonas aeruginosa: mechanisms and alternative therapeutic strategies. Biotechnol Adv 2019; 37(1):177-92. doi: 10.1016/j.biotechadv.2018.11.013 [Crossref] [ Google Scholar]
- Alavi M, Rai M. Recent advances in antibacterial applications of metal nanoparticles (MNPs) and metal nanocomposites (MNCs) against multidrug-resistant (MDR) bacteria. Expert Rev Anti Infect Ther 2019; 17(6):419-28. doi: 10.1080/14787210.2019.1614914 [Crossref] [ Google Scholar]
- Shaikh S, Nazam N, Rizvi SMD, Ahmad K, Baig MH, Lee EJ. Mechanistic insights into the antimicrobial actions of metallic nanoparticles and their implications for multidrug resistance. Int J Mol Sci 2019; 20(10):2468. doi: 10.3390/ijms20102468 [Crossref] [ Google Scholar]
- Alavi M, Nokhodchi A. An overview on antimicrobial and wound healing properties of ZnO nanobiofilms, hydrogels, and bionanocomposites based on cellulose, chitosan, and alginate polymers. Carbohydr Polym 2020; 227:115349. doi: 10.1016/j.carbpol.2019.115349 [Crossref] [ Google Scholar]
- Tavakoli S, Nemati S, Kharaziha M, Akbari-Alavijeh S. Embedding CuO nanoparticles in PDMS-SiO2 coating to improve antibacterial characteristic and corrosion resistance. Colloid Interface Sci Commun 2019; 28:20-8. doi: 10.1016/j.colcom.2018.11.002 [Crossref] [ Google Scholar]
- Taran M, Rad M, Alavi M. Biosynthesis of TiO(2) and ZnO nanoparticles by Halomonas elongata IBRC-M 10214 in different conditions of medium. Bioimpacts 2018; 8(2):81-9. doi: 10.15171/bi.2018.10 [Crossref] [ Google Scholar]
- Hussain A, Oves M, Alajmi MF, Hussain I, Amir S, Ahmed J. Biogenesis of ZnO nanoparticles using Pandanus odorifer leaf extract: anticancer and antimicrobial activities. RSC Adv 2019; 9(27):15357-69. doi: 10.1039/c9ra01659g [Crossref] [ Google Scholar]
- Elemike EE, Onwudiwe DC, Singh M. Eco-friendly synthesis of copper oxide, zinc oxide and copper oxide–zinc oxide nanocomposites, and their anticancer applications. J Inorg Organomet Polym Mater 2020; 30(2):400-9. doi: 10.1007/s10904-019-01198-w [Crossref] [ Google Scholar]
- Alavi M, Karimi N. Characterization, antibacterial, total antioxidant, scavenging, reducing power and ion chelating activities of green synthesized silver, copper and titanium dioxide nanoparticles using Artemisia haussknechtii leaf extract. Artif Cells Nanomed Biotechnol 2018; 46(8):2066-81. doi: 10.1080/21691401.2017.1408121 [Crossref] [ Google Scholar]
- Alavi M, Karimi N, Salimikia I. phytosynthesis of zinc oxide nanoparticles and its antibacterial, antiquorum sensing, antimotility, and antioxidant capacities against multidrug resistant bacteria. J Ind Eng Chem 2019; 72:457-73. doi: 10.1016/j.jiec.2019.01.002 [Crossref] [ Google Scholar]
- Alavi M, Karimi N. Ultrasound assisted-phytofabricated Fe(3)O(4) NPs with antioxidant properties and antibacterial effects on growth, biofilm formation, and spreading ability of multidrug resistant bacteria. Artif Cells Nanomed Biotechnol 2019; 47(1):2405-23. doi: 10.1080/21691401.2019.1624560 [Crossref] [ Google Scholar]
- Derwich E, Benziane Z, Boukir A. GC/MS analysis and antibacterial activity of the essential oil of Mentha pulegium grown in Morocco. Res J Agric Biol Sci 2010; 6(3):191-8. [ Google Scholar]
- Piras A, Porcedda S, Falconieri D, Maxia A, Gonçalves M, Cavaleiro C. Antifungal activity of essential oil from Mentha spicata L and Mentha pulegium L growing wild in Sardinia island (Italy). Nat Prod Res 2021; 35(6):993-9. doi: 10.1080/14786419.2019.1610755 [Crossref] [ Google Scholar]
- Ait-Ouazzou A, Lorán S, Arakrak A, Laglaoui A, Rota C, Herrera A. Evaluation of the chemical composition and antimicrobial activity of Mentha pulegium, Juniperus phoenicea, and Cyperus longus essential oils from Morocco. Food Res Int 2012; 45(1):313-9. doi: 10.1016/j.foodres.2011.09.004 [Crossref] [ Google Scholar]
- Kelkawi AHA, Abbasi Kajani A, Bordbar AK. Green synthesis of silver nanoparticles using Mentha pulegium and investigation of their antibacterial, antifungal and anticancer activity. IET Nanobiotechnol 2017; 11(4):370-6. doi: 10.1049/iet-nbt.2016.0103 [Crossref] [ Google Scholar]
- Hajlaoui H, Trabelsi N, Noumi E, Snoussi M, Fallah H, Ksouri R. Biological activities of the essential oils and methanol extract of tow cultivated mint species (Mentha longifolia and Mentha pulegium) used in the Tunisian folkloric medicine. World J Microbiol Biotechnol 2009; 25(12):2227-38. doi: 10.1007/s11274-009-0130-3 [Crossref] [ Google Scholar]
- Khaled-Khodja N, Boulekbache-Makhlouf L, Madani K. Phytochemical screening of antioxidant and antibacterial activities of methanolic extracts of some Lamiaceae. Ind Crops Prod 2014; 61:41-8. doi: 10.1016/j.indcrop.2014.06.037 [Crossref] [ Google Scholar]
- Alavi M, Karimi N, Salimikia I. Phytosynthesis of zinc oxide nanoparticles and its antibacterial, antiquorum sensing, antimotility, and antioxidant capacities against multidrug resistant bacteria. J Ind Eng Chem 2019; 72:457-73. doi: 10.1016/j.jiec.2019.01.002 [Crossref] [ Google Scholar]
- Alavi M, Karimi N. Antiplanktonic, antibiofilm, antiswarming motility and antiquorum sensing activities of green synthesized Ag-TiO(2), TiO(2)-Ag, Ag-Cu and Cu-Ag nanocomposites against multi-drug-resistant bacteria. Artif Cells Nanomed Biotechnol 2018; 46(Suppl 3):S399-S413. doi: 10.1080/21691401.2018.1496923 [Crossref] [ Google Scholar]
- Omidbakhsh N, Ahmadpour F, Kenny N. How reliable are ATP bioluminescence meters in assessing decontamination of environmental surfaces in healthcare settings?. PLoS One 2014; 9(6):e99951. doi: 10.1371/journal.pone.0099951 [Crossref] [ Google Scholar]
- Xu H, Liang J, Wang Y, Wang B, Zhang T, Liu X. Evaluation of different detector types in measurement of ATP bioluminescence compared to colony counting method for measuring bacterial burden of hospital surfaces. PLoS One 2019; 14(9):e0221665. doi: 10.1371/journal.pone.0221665 [Crossref] [ Google Scholar]
- Jadhav MS, Kulkarni S, Raikar P, Barretto DA, Vootla SK, Raikar US. Green biosynthesis of CuO & Ag–CuO nanoparticles from Malus domestica leaf extract and evaluation of antibacterial, antioxidant and DNA cleavage activities. New J Chem 2018; 42(1):204-13. doi: 10.1039/c7nj02977b [Crossref] [ Google Scholar]
- Gupta M, Tomar RS, Kaushik S, Mishra RK, Sharma D. Effective antimicrobial activity of green ZnO nano particles of Catharanthus roseus. Front Microbiol 2018; 9:2030. doi: 10.3389/fmicb.2018.02030 [Crossref] [ Google Scholar]
- Ezealisiji KM, Siwe-Noundou X, Maduelosi B, Nwachukwu N, Krause RWM. Green synthesis of zinc oxide nanoparticles using Solanum torvum (L) leaf extract and evaluation of the toxicological profile of the ZnO nanoparticles–hydrogel composite in Wistar albino rats. Int Nano Lett 2019; 9(2):99-107. doi: 10.1007/s40089-018-0263-1 [Crossref] [ Google Scholar]
- Vidovix TB, Quesada HB, Januário EFD, Bergamasco R, Vieira AMS. Green synthesis of copper oxide nanoparticles using Punica granatum leaf extract applied to the removal of methylene blue. Mater Lett 2019; 257:126685. doi: 10.1016/j.matlet.2019.126685 [Crossref] [ Google Scholar]
- Fakhari S, Jamzad M, Kabiri Fard H. Green synthesis of zinc oxide nanoparticles: a comparison. Green Chem Lett Rev 2019; 12(1):19-24. doi: 10.1080/17518253.2018.1547925 [Crossref] [ Google Scholar]
- Nagaraj E, Karuppannan K, Shanmugam P, Venugopal S. Exploration of bio-synthesized copper oxide nanoparticles using Pterolobium hexapetalum leaf extract by photocatalytic activity and biological evaluations. J Clust Sci 2019; 30(4):1157-68. doi: 10.1007/s10876-019-01579-8 [Crossref] [ Google Scholar]
- Sorbiun M, Shayegan Mehr E, Ramazani A, Taghavi Fardood S. Green synthesis of zinc oxide and copper oxide nanoparticles using aqueous extract of oak fruit hull (jaft) and comparing their photocatalytic degradation of basic violet 3. Int J Environ Res 2018; 12(1):29-37. doi: 10.1007/s41742-018-0064-4 [Crossref] [ Google Scholar]
- Rad M, Taran M, Alavi M. Effect of incubation time, CuSO4 and glucose concentrations on biosynthesis of copper oxide (CuO) nanoparticles with rectangular shape and antibacterial activity: Taguchi method approach. Nano Biomed Eng 2018; 10(1):25-33. doi: 10.5101/nbe.v10i1.p25-33 [Crossref] [ Google Scholar]
- Prasad AR, Garvasis J, Oruvil SK, Joseph A. Bio-inspired green synthesis of zinc oxide nanoparticles using Abelmoschus esculentus mucilage and selective degradation of cationic dye pollutants. J Phys Chem Solids 2019; 127:265-74. doi: 10.1016/j.jpcs.2019.01.003 [Crossref] [ Google Scholar]
- Bhattacharya P, Swarnakar S, Ghosh S, Majumdar S, Banerjee S. Disinfection of drinking water via algae mediated green synthesized copper oxide nanoparticles and its toxicity evaluation. J Environ Chem Eng 2019; 7(1):102867. doi: 10.1016/j.jece.2018.102867 [Crossref] [ Google Scholar]
- Alavi M, Karimi N. Biosynthesis of Ag and Cu NPs by secondary metabolites of usnic acid and thymol with biological macromolecules aggregation and antibacterial activities against multi drug resistant (MDR) bacteria. Int J Biol Macromol 2019; 128:893-901. doi: 10.1016/j.ijbiomac.2019.01.177 [Crossref] [ Google Scholar]
- Banerjee P, Satapathy M, Mukhopahayay A, Das P. Leaf extract mediated green synthesis of silver nanoparticles from widely available Indian plants: synthesis, characterization, antimicrobial property and toxicity analysis. Bioresour Bioprocess 2014; 1(1):3. doi: 10.1186/s40643-014-0003-y [Crossref] [ Google Scholar]
- Bindhu MR, Umadevi M, Esmail GA, Al-Dhabi NA, Arasu MV. Green synthesis and characterization of silver nanoparticles from Moringa oleifera flower and assessment of antimicrobial and sensing properties. J Photochem Photobiol B 2020; 205:111836. doi: 10.1016/j.jphotobiol.2020.111836 [Crossref] [ Google Scholar]
- Alavi M, Karimi N, Valadbeigi T. Antibacterial, antibiofilm, antiquorum sensing, antimotility, and antioxidant activities of green fabricated Ag, Cu, TiO(2), ZnO, and Fe(3)O(4) NPs via Protoparmeliopsis muralis lichen aqueous extract against multi-drug-resistant bacteria. ACS Biomater Sci Eng 2019; 5(9):4228-43. doi: 10.1021/acsbiomaterials.9b00274 [Crossref] [ Google Scholar]
- Khatami M, Heli H, Mohammadzadeh Jahani P, Azizi H, Lima Nobre MA. Copper/copper oxide nanoparticles synthesis using Stachys lavandulifolia and its antibacterial activity. IET Nanobiotechnol 2017; 11(6):709-13. doi: 10.1049/iet-nbt.2016.0189 [Crossref] [ Google Scholar]
- Aziz WJ, Abid MA, Hussein EH. Biosynthesis of CuO nanoparticles and synergistic antibacterial activity using mint leaf extract. Mater Technol 2020; 35(8):447-51. doi: 10.1080/10667857.2019.1692163 [Crossref] [ Google Scholar]
- Taran M, Rad M, Alavi M. Antibacterial activity of copper oxide (CuO) nanoparticles biosynthesized by Bacillus sp FU4: optimization of experiment design. Pharm Sci 2017; 23(3):198-206. doi: 10.15171/ps.2017.30 [Crossref] [ Google Scholar]
- Chauhan M, Sharma B, Kumar R, Chaudhary GR, Hassan AA, Kumar S. Green synthesis of CuO nanomaterials and their proficient use for organic waste removal and antimicrobial application. Environ Res 2019; 168:85-95. doi: 10.1016/j.envres.2018.09.024 [Crossref] [ Google Scholar]
- Duffy LL, Osmond-McLeod MJ, Judy J, King T. Investigation into the antibacterial activity of silver, zinc oxide and copper oxide nanoparticles against poultry-relevant isolates of Salmonella and Campylobacter. Food Control 2018; 92:293-300. doi: 10.1016/j.foodcont.2018.05.008 [Crossref] [ Google Scholar]
- Ali K, Ahmed B, Ansari SM, Saquib Q, Al-Khedhairy AA, Dwivedi S. Comparative in situ ROS mediated killing of bacteria with bulk analogue, Eucalyptus leaf extract (ELE)-capped and bare surface copper oxide nanoparticles. Mater Sci Eng C Mater Biol Appl 2019; 100:747-58. doi: 10.1016/j.msec.2019.03.012 [Crossref] [ Google Scholar]
- Alavi M, Rai M. Recent progress in nanoformulations of silver nanoparticles with cellulose, chitosan, and alginic acid biopolymers for antibacterial applications. Appl Microbiol Biotechnol 2019; 103(21-22):8669-76. doi: 10.1007/s00253-019-10126-4 [Crossref] [ Google Scholar]